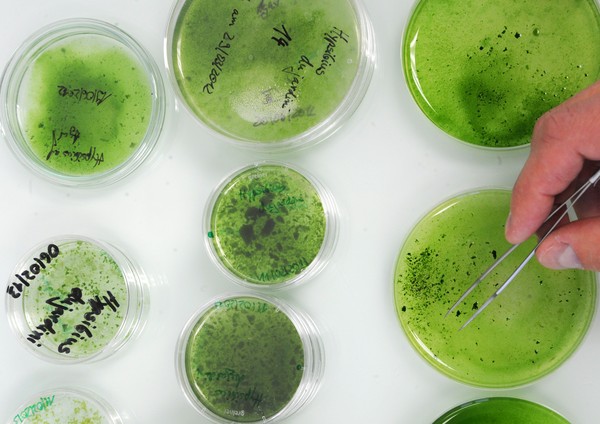

★公众号:寰宇科学(点击复制)微信
水熊虫就算地球人类全毁灭还能再活100亿年
2017-7-15 寰宇科学
这样的生物实在是太厉害了!适应能力不是一般的强啊,而且身型特别小,耐热耐寒,只要太阳在它能一直生存下去,听起来是不是很厉害,这应该是地球最牛的生物了吧!如果把它们的这些能力运用到合适的地方,那就更好了!
水熊虫最长只能达到0.05厘米。
俗称水熊虫(Water Bears)的物种长度最长只能达到0.05厘米,在没有食物水的情况下能存活30年、耐热至150度,在冷冻的条件仍然能够交配;只要太阳不死,最少还能再活个100亿年!
水熊虫的种类将近一千多种,体长小于0.05厘米,有8只脚,可以忍受严寒、酷热的温度,甚至是在辐射照射下的情况下生存。最令人惊讶的是,水熊虫还能将对自身不利的DNA去除掉,制造具有破坏性过氧化氢分子的DNA ,再将基因重组。
水熊生存力几近无敌,科学家:基因片段转移成人类保命希望。

研究指出,超新星的爆炸、陨石撞地球等大规模的天文物理灾难,都有可能造成地球的毁灭。牛津大学学者(Rafael Alves Batista)更表示,人类属于敏感的物种,环境只要有些微的变化,都能对我们造成巨大的影响,这种物理灾难很容易把人类消灭。
不过“水熊虫”却有可能因为自身优势,在这些灾难中幸存。在它们身上的基因中,有一部分的DNA能撑过严苛的环境,让细胞不会受到太多的损伤。据悉,东京大学研究团队希望能够将“水熊虫”的基因片段,转移到人类细胞上,让人类也能拥有如“水熊虫”般一样强韧的生命力。
水熊虫会随着环境演化出各种生存能力。


共有555阅 / 0评我要评论
发表你的评论吧返回顶部
!评论内容需包含中文
